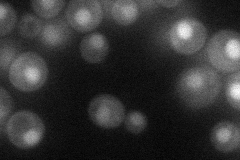
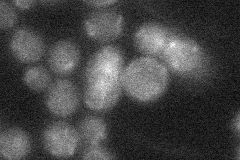
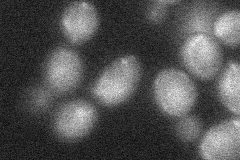

View description
Negative regulator of glucose-induced cAMP signaling; directly activates the GTPase activity of the heterotrimeric G protein alpha subunit Gpa2p
Localization:
Intensity:
Fold change:
Significance:
-
C’ GFP library in SD

nucleus20.29 -
N' NOP1pr-GFP in SD
nucleus33.7591 -
N' TEF2pr-mCherry in SD

nucleus14.5191 -
N' NATIVEpr-GFP in SD
below threshold20.0305 -
N' TEF2pr-VC and Cyto-VN in SD
below threshold25.3196 -
C’ GFP library in SD+DTT

nucleus17.90.88No -
C’ GFP library in SD+H2O2

nucleus21.531.06No -
C’ GFP library in Starvation Media

nucleus20.381No -
C’ GFP library on the background of Pup2-DaMP

nucleus -
C’ GFP library on the background of CCT mutant

nucleus20.02140.98629No
